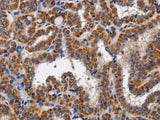
KLK6 Polyclonal Antibody Store at -20°C

KLK6 Polyclonal Antibody Store at -20°C
SKU: E-AB-11356-200
KLK6 Polyclonal Antibody Store at -20°C
| SKU # | E-AB-11356 |
| Reactivity | Human |
| Host | Rabbit |
| Applications | IHC |
Product Details
| Isotype | IgG |
| Host | Rabbit |
| Reactivity | Human |
| Applications | IHC |
| Clonality | Polyclonal |
| Immunogen | Recombinant protein of human KLK6 |
| Abbre | KLK6 |
| Synonyms | Bssp, KLK 6, KLK 9, KLK6, KLK9, Kallikrein 6 precursor, Kallikrein related peptidase 6, Kallikrein-6, Kallikrein6, Klk 7, Klk29, Klk6, Klk7, MGC9355, MSP, Neurosin, PRSS 18, PRSS 9, PRSS18, PRSS9, Protease M, Protease serine 18, Protease serine 9, Serine pro, hK 6, hK6, mGK 1, mGK1 |
| Swissprot | |
| Cellular Localization | Secreted. Nucleus>nucleolus. Cytoplasm. Mitochondrion. Microsome. In brain, detected in the nucleus of glial cells and in the nucleus and cytoplasm of neurons. Detected in the mitochondrial and microsomal fractions of HEK-293 cells and released into the cytoplasm following cell stress. |
| Concentration | 0.4 mg/mL |
| Buffer | Phosphate buffered solution, pH 7.4, containing 0.05% stabilizer and 50% glycerol. |
| Purification Method | Affinity purification |
| Research Areas | Cancer, Cell Biology, Neuroscience, Signal Transduction |
| Conjugation | Unconjugated |
| Storage | Store at -20°C Valid for 12 months. Avoid freeze / thaw cycles. |
| Shipping | The product is shipped with ice pack, upon receipt,s tore it immediately at the temperature recommended. |
Related Reagents
| Applications | Recommended Dilution |
| IHC | 1:100-1:300 |
Background
Kallikreins are a subgroup of serine proteases having diverse physiological functions. Growing evidence suggests that many kallikreins are implicated in carcinogenesis and some have potential as novel cancer and other disease biomarkers. This gene is one of the fifteen kallikrein subfamily members located in a cluster on chromosome 19. The encoded enzyme is regulated by steroid hormones. In tissue culture, the enzyme has been found to generate amyloidogenic fragments from the amyloid precursor protein, suggesting a potential for involvement in Alzheimer's disease. Multiple alternatively spliced transcript variants that encode different isoforms have been identified for this gene.